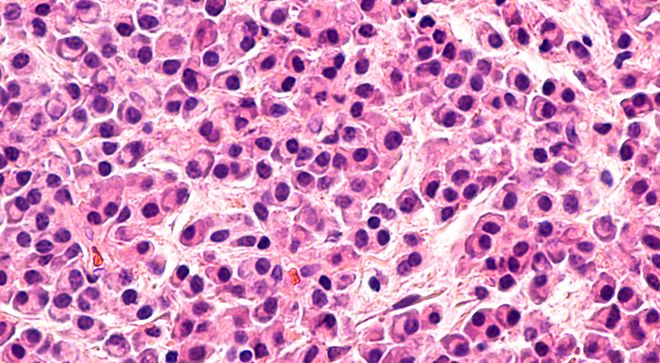

Myeloma
Latest News
Latest Videos

More News

Data from the MajesTEC-1 trial shows that patients with relapsed/refractory multiple myeloma responded to Tecvalyi for a median of two years and lived without disease progression for nearly a year.

Sarclisa, Velcade, Revlimid and dexamethasone improved progression-free survival in patients with multiple myeloma who were not eligible for transplant.

Belamaf plus bortezomib and dexamethasone lengthened the time patients with relapsed or refractory myeloma lived before their disease got worse.

Blenrep, Pomalyst and dexamethasone improved progression-free survival compared to Velcade, Pomalyst and dexamethasone in patients with relapsed/refractory myeloma.

Sarclisa was granted a priority review by the Food and Drug Administration for patients newly diagnosed with multiple myeloma who are ineligible for blood transplants.

Here’s a look at therapies the FDA approved in the blood cancer space over the last few months.

Using tests to identify minimal residual disease may help determine how much treatment patients with multiple myeloma require.

Tecvayli responses were found to be slightly lower in patients with relapsed/refractory myeloma treated with another BCMA-targeted therapy.

I need to acknowledge and address the impact stress from multiple myeloma has on my mental and emotional wellbeing.

For patients with lymphoma or multiple myeloma, speaking up about symptoms of cytokine release syndrome can be lifesaving.

With Carvykti now approved for pretreated myeloma, there are conversations that patients should have with their providers before treatment, a nurse said.

Patients with heavily pretreated myeloma tended to have “really amazing results” with the CAR-T cell therapy, Carvykti.

After cancer, I've been learning to maintain a positive attitude regarding my self-image and rehabilitation.

The Food and Drug Administration approved the CAR-T cell therapy, Carvykti, for previously treated patients with multiple myeloma.

The Food and Drug Administration approved Abecma for adults with relapsed or refractory multiple myeloma who have received two or more previous lines of therapy.

There is no difference in treatment for non-secretory multiple myeloma and multiple myeloma, an expert told CURE®.

Of everything I've ever done, I wonder how my multiple myeloma came to be.

An FDA committee voted that the benefits of Carvykti outweigh the risks for myeloma treatment, though concerns about secondary malignancies remain.

Here is a run-down of some topics we covered in the Spring 2024 issue of CURE.

Eating a plant-based diet has been associated with sustained MRD negativity for patients with multiple myeloma.

The BCMA protein has become the primary target for treating multiple myeloma, resulting in longer survival and more manageable side effects.

This poem was written in hope that those experiencing multiple myeloma, or other cancers, will find solace in knowing that advancements in treatments are being made every day, and a positive attitude with caregiver acceptance and support will prolong one’s days for a productive life.

Even though multiple myeloma had devastating effects on my collapsed lungs, singing has helped regain my sense of strength and resilience.
Most patients with relapsed or refractory multiple myeloma responded to treatment with the CAR-T cell therapy, Carvykti, according to a small study.

The Food and Drug Administration is reviewing the novel drug, linvoseltamab, for the treatment of patients with pretreated, relapsed or refractory multiple myeloma.
















